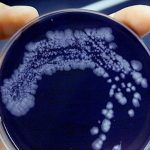

Sarà il 20 febbraio di ogni anno la “Giornata del personale sanitario e sociosanitario” (A.C. 2527) e in coordinamento con gli ordini delle professioni sanitarie e sociosanitarie, con le associazioni e gli organismi del settore sarà un “momento – come dice il testo approvato in Commissione Affari sociali alla Camera in sede legislativa – per onorare il lavoro, l’impegno, la professionalità e il sacrificio nel corso della pandemia da coronavirus nell’anno 2020”.
La Commissione ha modificato il titolo originario, su proposta dei relatori, anche dietro segnalazione e confronto avviato con la FNOPI, rendendo esplicita l’estensione e applicazione della ricorrenza a tutto il personale sanitario e sociosanitario che durante la pandemia ha assistito i cittadini.
“E’ un successo di tutte le professioni sanitarie e sociosanitarie – afferma Barbara Mangiacavalli, presidente della Federazione nazionale degli ordini delle professioni infermieristiche (FNOPI) – in prima linea nella lotta alla pandemia. Gli infermieri, ad esempio, rappresentano il 61% delle professioni sanitarie e hanno pagato un prezzo altissimo: 42 morti, 4 suicidi e oltre 16mila contagiati fino a oggi“.
“E’ un atto che rende merito ai tanti operatori sanitari impegnati nella lotta a COVID – aggiunge – molti dei quali hanno anche contratto il virus, un gran numero in tutte le professioni, molti sono deceduti e mai nessuno nonostante tutto ha abbandonato un solo istante la prima linea e per questo è giusto che la legge li comprenda davvero tutti”.
“Ringraziamo i parlamentari che hanno recepito e approvato le integrazioni del relatore e hanno permesso questa forma di riconoscimento di tutte le professionalità”, afferma Mangiacavalli.
“Ci auguriamo adesso – conclude – che nel passaggio finale al Senato sia recepito questo ultimo testo e che la Gionata sia, anche formalmente, il riconoscimento di tutti gli operatori sanitari in prima linea nella lotta alla pandemia. Gli infermieri che sono tra i primi ad affrontare la lotta a COVID-19 sono anche i primi a esserne orgogliosi”.

Lascia un commento